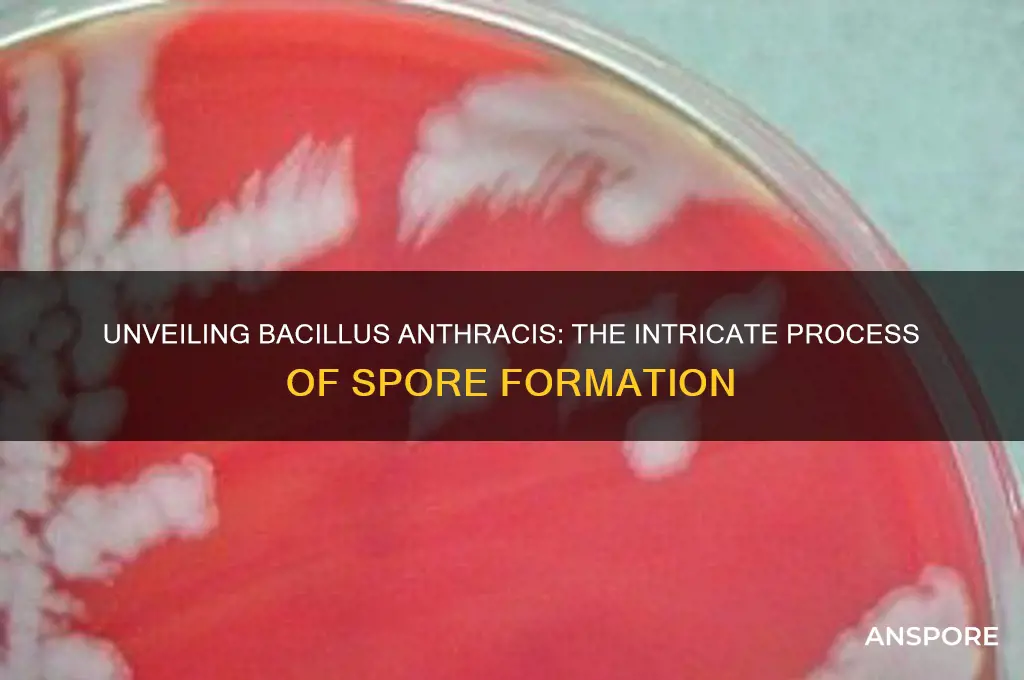
how do bacillus anthracis make spores

*Bacillus anthracis*, the bacterium responsible for anthrax, is a spore-forming pathogen that produces highly resilient endospores as part of its life cycle. Under unfavorable environmental conditions, such as nutrient depletion or desiccation, *B. anthracis* initiates sporulation, a complex and tightly regulated process. This process involves the formation of a protective spore within the bacterial cell, which consists of multiple layers, including a thick spore coat and an outer exosporium. These layers provide resistance to harsh conditions, such as heat, radiation, and disinfectants, allowing the spores to persist in the environment for decades. The ability to form spores is crucial for the bacterium's survival and transmission, as spores can easily contaminate soil, animal products, and other materials, posing a significant risk to both animal and human health. Understanding the sporulation process of *B. anthracis* is essential for developing effective strategies to detect, prevent, and treat anthrax infections.
| Characteristics | Values |
|---|---|
| Sporulation Process | Complex, multi-stage process triggered by nutrient depletion and other environmental stresses. |
| Initiation | Depends on sigma factors (σH, σE, σK, σG) that activate specific genes in a cascade. |
| Asymmetric Cell Division | The cell divides unevenly, forming a smaller forespore and a larger mother cell. |
| Engulfment | The mother cell engulfs the forespore, creating a double-membrane structure. |
| Cortex and Coat Formation | The forespore synthesizes a thick peptidoglycan cortex and a proteinaceous coat. |
| Exosporium Formation | An outer layer, the exosporium, is formed around the mature spore, composed of proteins and carbohydrates. |
| Dehydration and Dormancy | The spore dehydrates, becoming metabolically dormant and highly resistant to harsh conditions. |
| Resistance Mechanisms | Resistant to heat, radiation, desiccation, and many chemicals due to the cortex, coat, and exosporium. |
| Germination | Spores can germinate and return to vegetative growth when exposed to favorable conditions (nutrients, warmth, moisture). |
Explore related products
What You'll Learn
- Sporulation initiation: Environmental triggers like nutrient depletion activate sporulation genes in B. anthracis
- Asymmetric cell division: The cell divides unevenly, forming a small forespore and larger mother cell
- Forespore engulfment: The mother cell engulfs the forespore, creating a double-membrane structure
- Cortex and coat synthesis: Protective layers (cortex, coat) are synthesized around the developing spore
- Maturation and release: The mature spore is released after mother cell lysis, becoming highly resistant

Sporulation initiation: Environmental triggers like nutrient depletion activate sporulation genes in B. anthracis
Bacillus anthracis, the bacterium responsible for anthrax, employs a sophisticated survival strategy when faced with adversity: sporulation. This process, triggered by environmental cues like nutrient depletion, ensures the bacterium's persistence in harsh conditions. When nutrients become scarce, B. anthracis senses this change through intricate signaling pathways, primarily involving the phosphorylation cascade of the Spo0A protein. This master regulator, once activated, initiates a genetic program that redirects the cell's resources toward spore formation.
Understanding this trigger mechanism is crucial for developing strategies to disrupt sporulation, potentially weakening the bacterium's ability to survive and cause disease.
The process begins with the depletion of key nutrients, particularly carbon and nitrogen sources. As these resources dwindle, the bacterium's metabolism shifts, leading to the accumulation of signaling molecules like guanosine pentaphosphate (ppGpp). This alarmone binds to and activates the kinase KinA, which phosphorylates Spo0A. Phosphorylated Spo0A then binds to specific DNA sequences, activating genes involved in spore formation. This intricate dance of molecular signals highlights the bacterium's remarkable ability to adapt to its environment.
From a practical standpoint, disrupting this nutrient-sensing pathway could be a viable strategy for controlling B. anthracis. For instance, research has shown that certain small molecules can inhibit KinA activity, thereby preventing Spo0A phosphorylation and sporulation. Additionally, environmental interventions, such as controlled nutrient availability, could be explored in containment strategies. For example, in laboratory settings, sporulation can be induced by culturing B. anthracis in nutrient-limited media, such as SPYCE (Sporulation Promoting Yeast Extract) medium, which contains reduced levels of carbon and nitrogen sources.
Comparatively, other Bacillus species, like B. subtilis, share similar sporulation mechanisms but differ in their specific environmental triggers and regulatory networks. While B. subtilis sporulates in response to a broader range of stressors, B. anthracis is more narrowly tuned to nutrient depletion, reflecting its ecological niche. This specificity makes B. anthracis a unique model for studying how environmental cues dictate bacterial survival strategies.
In conclusion, sporulation initiation in B. anthracis is a finely tuned response to nutrient depletion, orchestrated by a complex network of molecular signals. By targeting key components of this pathway, such as Spo0A or KinA, researchers can develop novel strategies to inhibit spore formation, potentially mitigating the bacterium's threat. Practical applications, from laboratory induction methods to environmental control measures, underscore the importance of understanding this process in both scientific and applied contexts.
Mould Spores and Eye Health: Risks, Symptoms, and Prevention Tips
You may want to see also

Asymmetric cell division: The cell divides unevenly, forming a small forespore and larger mother cell
Bacillus anthracis, the bacterium responsible for anthrax, employs a sophisticated process to create spores, its survival form. Central to this process is asymmetric cell division, a mechanism where the cell divides unevenly, producing a small forespore and a larger mother cell. This division is not merely a random event but a highly regulated process that ensures the forespore’s transformation into a resilient spore capable of withstanding harsh environmental conditions.
Consider the steps involved in this asymmetric division. It begins with the activation of a genetic program triggered by nutrient deprivation or other environmental stressors. The cell’s DNA replicates, and the division septum forms off-center, creating the forespore and mother cell. The forespore, though smaller, is the future spore, while the mother cell’s primary role is to nurture and protect the forespore during its maturation. This division is orchestrated by proteins like SpoIIE and SpoIIQ, which ensure the septum’s precise placement and maintain communication between the two compartments.
Analyzing this process reveals its efficiency and purpose. The mother cell acts as a sacrificial entity, providing the forespore with essential nutrients and protective layers, including a thick peptidoglycan cortex and a proteinaceous coat. This asymmetric division is not just about size disparity but about functional specialization. The forespore undergoes a series of morphological changes, including dehydration and the synthesis of dipicolinic acid, which stabilizes its DNA. Meanwhile, the mother cell lyses, releasing a mature spore capable of surviving for decades in adverse conditions.
Practical implications of understanding this process extend to bioterrorism preparedness and medical treatment. For instance, disrupting the asymmetric division or the mother cell’s function could prevent spore formation, a potential target for antimicrobial strategies. Researchers have explored inhibitors of SpoIIE or SpoIIQ, aiming to block spore development in B. anthracis. Additionally, knowing the spore’s resilience informs decontamination protocols, such as using autoclaving at 121°C for 30 minutes to ensure spore inactivation.
In comparison to symmetric cell division, which produces two identical daughter cells, asymmetric division in B. anthracis is a strategic adaptation for survival. While symmetric division supports growth and proliferation, asymmetric division ensures long-term persistence in hostile environments. This distinction highlights the bacterium’s evolutionary ingenuity, tailoring its division mechanism to its ecological niche. By focusing on this unique process, we gain insights into both the bacterium’s biology and potential vulnerabilities, paving the way for targeted interventions.
Inoculating LC Cultures: Using Spores for Successful Growth and Maintenance
You may want to see also

Forespore engulfment: The mother cell engulfs the forespore, creating a double-membrane structure
Bacillus anthracis, the bacterium responsible for anthrax, employs a sophisticated process to form spores, ensuring its survival in harsh conditions. A critical step in this process is forespore engulfment, where the mother cell envelops the developing forespore, creating a double-membrane structure. This mechanism is not merely a passive event but a highly regulated, dynamic process essential for spore maturation. Understanding this step provides insights into the bacterium's resilience and potential vulnerabilities.
Analytically, forespore engulfment is a cellular ballet orchestrated by a cascade of proteins and genetic signals. The mother cell recognizes the forespore through specific surface markers, initiating a phagocytosis-like process. This engulfment results in the forespore becoming encased within two membranes: the inner membrane derived from the forespore itself and the outer membrane contributed by the mother cell. This double-membrane structure is crucial for protecting the developing spore from environmental stressors, such as desiccation, heat, and chemicals. The precision of this process highlights the bacterium's evolutionary adaptation to survive in adverse conditions.
Instructively, researchers studying this process often use genetic tools to manipulate the proteins involved in engulfment. For instance, disrupting genes like *spoIIQ* or *spoIIIE* can halt the engulfment process, providing a clearer understanding of each protein's role. Practical tips for laboratory studies include using fluorescent markers to visualize the membranes during engulfment and employing time-lapse microscopy to observe the process in real time. These techniques not only deepen our understanding but also pave the way for developing targeted interventions to disrupt spore formation.
Comparatively, forespore engulfment in B. anthracis shares similarities with phagocytosis in eukaryotic cells, yet it is uniquely tailored to the bacterial context. Unlike phagocytosis, which often leads to degradation, engulfment in spore formation is a protective mechanism. This distinction underscores the bacterium's ability to repurpose cellular processes for survival. By studying these differences, scientists can identify unique targets for antimicrobial therapies that specifically disrupt spore formation without affecting other cellular processes.
Descriptively, the double-membrane structure formed during engulfment resembles a cocoon, shielding the forespore from external threats. The outer membrane acts as a barrier, while the inner membrane maintains the forespore's integrity. This dual-layer protection is akin to a fortress, with each layer serving a distinct purpose. Over time, the mother cell lyses, releasing the mature spore into the environment, ready to withstand extreme conditions until it encounters favorable conditions for germination. This final step ensures the bacterium's longevity and underscores the importance of engulfment in the spore formation process.
Can Mold Spores Stick to Your Skin? Uncovering the Truth
You may want to see also
Explore related products

Cortex and coat synthesis: Protective layers (cortex, coat) are synthesized around the developing spore
The formation of spores in *Bacillus anthracis* is a complex process, and the synthesis of the cortex and coat layers is a critical step in ensuring the spore's survival. As the spore develops, it becomes surrounded by these protective layers, which serve as a barrier against environmental stressors such as heat, desiccation, and chemicals. The cortex, a thick layer of modified peptidoglycan, provides structural support and helps maintain spore shape, while the coat, a proteinaceous outer layer, offers additional protection and plays a role in spore germination.
The Cortex: A Structural Fortress
Imagine a medieval castle's walls, designed to withstand siege and assault. The cortex of a *B. anthracis* spore serves a similar purpose, providing a robust structural framework that protects the delicate inner contents. This layer is synthesized through a carefully orchestrated process, involving the coordinated activity of various enzymes and proteins. One key player is the MurA enzyme, which catalyzes the first committed step in peptidoglycan biosynthesis, ensuring the cortex's rapid assembly around the developing spore. The cortex's thickness and composition are crucial; a study published in *Journal of Bacteriology* (2018) found that spores with a thinner cortex were more susceptible to heat and chemical stressors, highlighting the importance of this layer's integrity.
Coat Assembly: A Complex Protein Puzzle
The coat layer, on the other hand, is a intricate mosaic of proteins, each with specific functions and interactions. This layer is assembled through a hierarchical process, where proteins are recruited and organized in a precise manner. The coat's composition is highly regulated, with over 70 proteins identified in the *B. anthracis* spore coat. These proteins are synthesized in the mother cell and then transported to the developing spore, where they self-assemble into a complex, multilayered structure. A review in *Nature Reviews Microbiology* (2014) emphasizes the coat's role in spore germination, suggesting that specific coat proteins interact with germinant receptors, triggering the spore's return to vegetative growth.
Practical Implications and Applications
Understanding the synthesis of the cortex and coat layers has significant implications for developing strategies to combat *B. anthracis* spores. For instance, researchers are exploring the potential of targeting coat proteins to inhibit spore germination, thereby preventing anthrax infection. A study in *PLOS Pathogens* (2016) identified a small molecule that disrupts coat assembly, rendering spores unable to germinate. This approach could lead to the development of novel therapeutics or decontamination strategies. Furthermore, knowledge of cortex and coat synthesis can inform the design of more effective spore inactivation methods, such as optimized heat or chemical treatments that specifically target these protective layers. By unraveling the intricacies of cortex and coat synthesis, scientists can develop more targeted and effective approaches to neutralize the threat posed by *B. anthracis* spores.
Comparative Analysis and Future Directions
Comparing the cortex and coat synthesis in *B. anthracis* with other spore-forming bacteria reveals both conserved and unique features. For example, while the cortex composition is similar across species, the coat proteins exhibit significant diversity, reflecting adaptations to specific environmental niches. This comparative analysis highlights the importance of studying *B. anthracis* spore formation in its own right, as well as in the broader context of spore biology. Future research should focus on elucidating the regulatory mechanisms governing cortex and coat synthesis, identifying novel proteins involved in these processes, and exploring the potential of targeting these layers for anthrax prevention and treatment. By doing so, we can develop a more comprehensive understanding of *B. anthracis* spore formation and inform the development of effective countermeasures against this deadly pathogen.
Do Spores Share Identical DNA with Their Vegetative State?
You may want to see also

Maturation and release: The mature spore is released after mother cell lysis, becoming highly resistant
The final stage of spore formation in *Bacillus anthracis* is a dramatic event, akin to a cellular explosion. The mother cell, having nurtured the developing spore, undergoes lysis—a process of self-destruction—to release the mature spore into the environment. This act of sacrifice is not in vain; it marks the emergence of a highly resistant life form capable of surviving extreme conditions. The spore, now free, is a testament to the bacterium's resilience, armed with a durable coat that shields it from desiccation, heat, and chemicals.
A Strategic Survival Mechanism
This release mechanism is a strategic move in the bacterium's survival playbook. By lysing the mother cell, *B. anthracis* ensures the spore's immediate exposure to the external environment, triggering its transition into a dormant, resilient state. The spore's resistance is not just a passive feature but an active response to the sudden change in its surroundings. This process is crucial for the bacterium's longevity, especially in harsh conditions where the vegetative form would perish.
The Science Behind Spore Resistance
The mature spore's resistance is a result of its unique structure. It comprises multiple layers, including a thick peptidoglycan cortex and a proteinaceous coat, which provide a formidable barrier against environmental stressors. This coat is not just a physical shield; it also contains enzymes and proteins that contribute to the spore's longevity. For instance, dipicolinic acid, a calcium-chelating agent, is present in high concentrations within the spore core, playing a pivotal role in maintaining spore dormancy and resistance.
Practical Implications and Safety Measures
Understanding this maturation and release process is not merely academic; it has significant implications for public health and safety. *B. anthracis* spores are notorious for their ability to cause anthrax, a potentially fatal disease. The spores' resistance allows them to persist in soil for decades, posing a long-term threat. In the event of a suspected or confirmed anthrax outbreak, decontamination efforts must consider the spores' resilience. Effective decontamination requires specialized procedures, such as autoclaving at 121°C for 30 minutes or the use of strong chemical disinfectants like formaldehyde or hydrogen peroxide, to ensure the destruction of these highly resistant spores.
A Natural Wonder with Dual Implications
The maturation and release of *B. anthracis* spores showcase the bacterium's remarkable adaptability. This natural process, while fascinating from a biological perspective, underscores the importance of vigilance in handling and studying such organisms. The very features that make these spores a scientific wonder also demand respect and caution, highlighting the dual nature of biological research—uncovering the secrets of life while safeguarding against its potential threats.
Are Conidia Spores Sexual? Unraveling Fungal Reproduction Mysteries
You may want to see also
Frequently asked questions
Bacillus anthracis forms spores in response to environmental stress, such as nutrient depletion, desiccation, or other unfavorable conditions. This process, known as sporulation, is a survival mechanism to ensure the bacterium's long-term persistence.
Bacillus anthracis produces spores through a complex, multi-stage process called sporulation. It involves asymmetric cell division, formation of a spore within the mother cell, and the synthesis of protective layers, including a thick spore coat and exosporium, to ensure durability and resistance to harsh conditions.
Yes, Bacillus anthracis spores are highly infectious and can cause anthrax when inhaled, ingested, or introduced through skin wounds. Spores can survive in the environment for decades, remaining dormant until they encounter favorable conditions to germinate and resume vegetative growth.

























